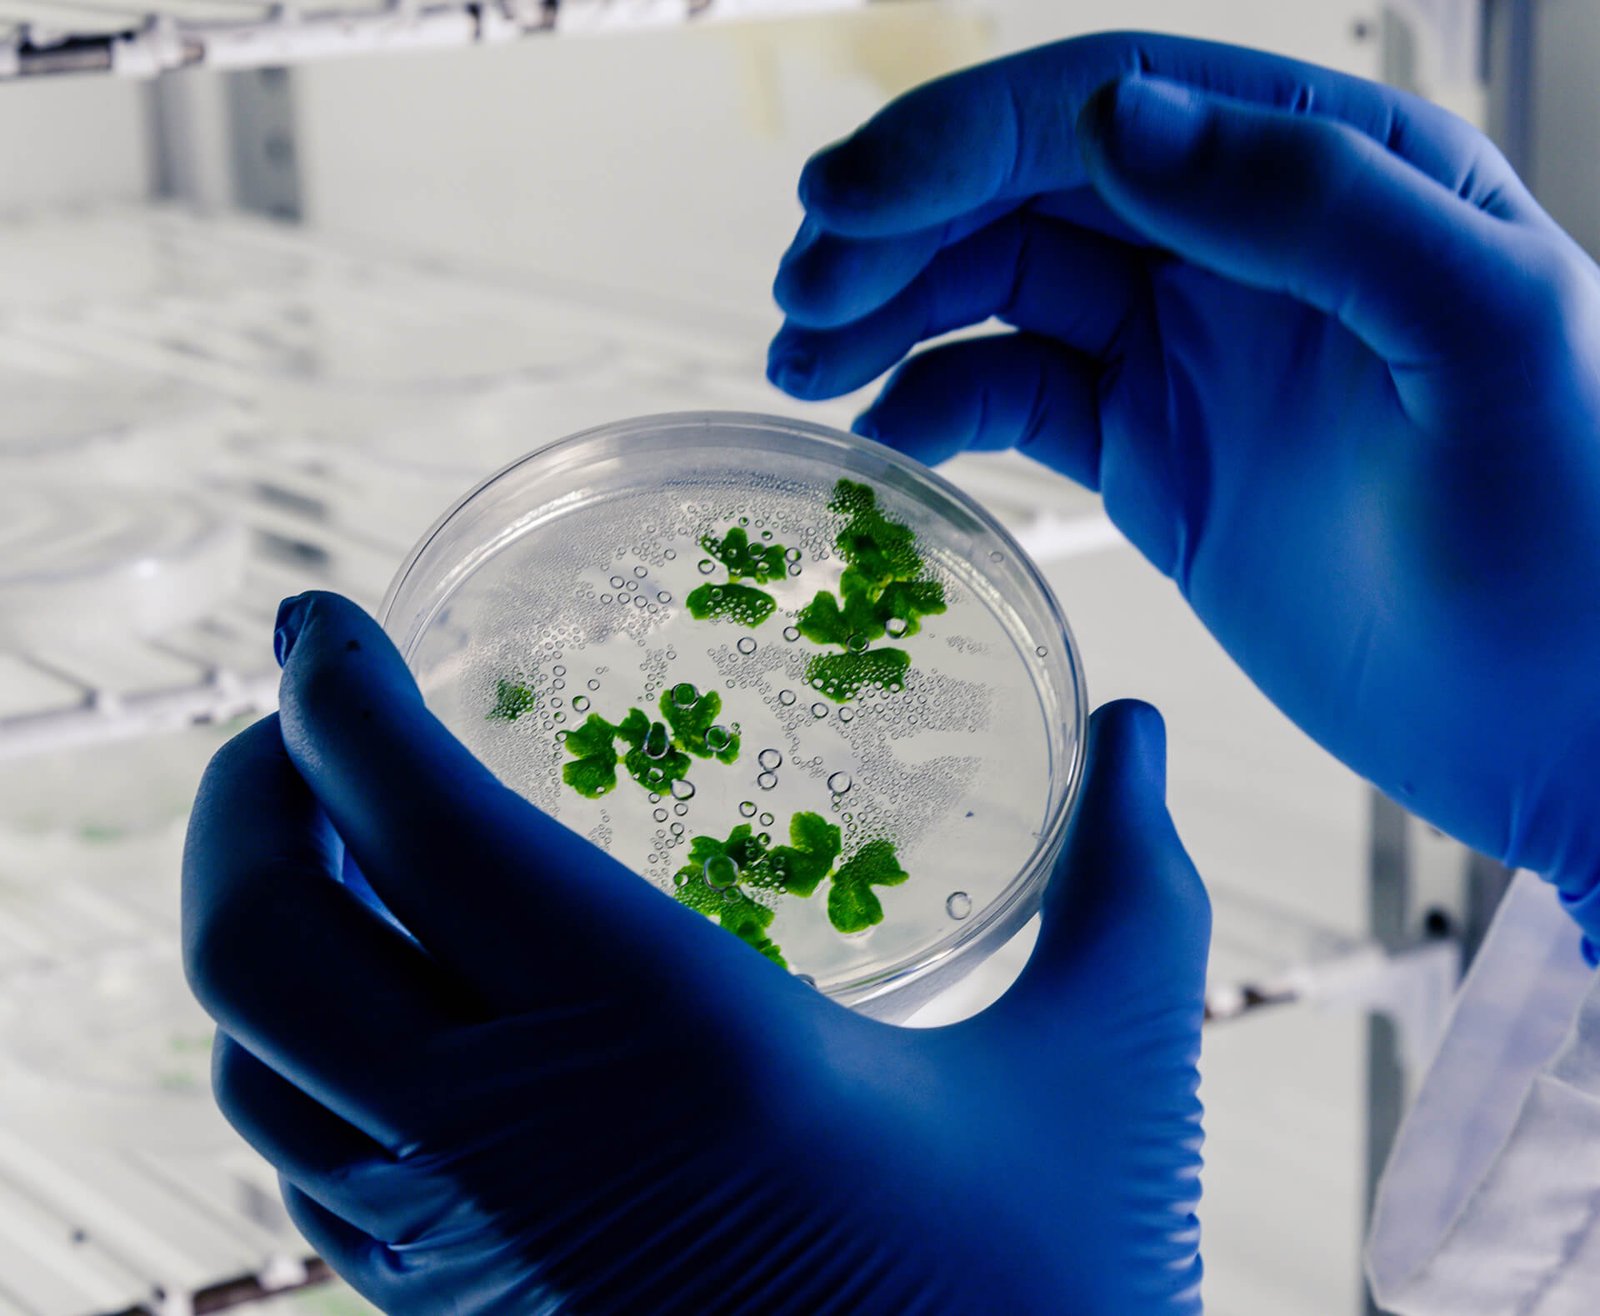

30+
PSA Oksijen Jeneratör Serilerimiz
S Serisi 0,60 - 3,60 Nm³/saat
Küçük ölçekli sağlık kurumları ve ev tipi çözümler için
A Serisi 4,20 - 42 Nm³/saat
Klinikler ve orta büyüklükte tesisler için
E Serisi 51 - 70 Nm³/saat
Büyük hastaneler ve sanayi uygulamaları için
L Serisi 72 - 150 Nm³/saat
Yüksek hacimli endüstriyel üretimler için
PSA Oksijen Jeneratör Modellerimiz
- Kurumsal
- PSA Oksijen Jeneratörleri
- Geri
- PSA Oksijen Jeneratör Serilerimiz
- Geri
- PSA Oksijen Jeneratörleri – S SerisiKüçük ölçekli sağlık kurumları ve ev tipi çözümler için
- PSA Oksijen Jeneratörleri – A SerisiKlinikler ve orta büyüklükte tesisler için
- PSA Oksijen Jeneratörleri – E SerisiBüyük hastaneler ve sanayi uygulamaları için
- PSA Oksijen Jeneratörleri – L SerisiYüksek hacimli endüstriyel üretimler için
- Tümünü Görüntüle
- PSA Oksijen Jeneratör Modellerimiz
- Geri
- Modüler ModelKompakt, Taşınabilir ve Modüler Oksijen Çözümleri
- Mobil ModellerOksijen Üretiminde Taşınabilir ve Kesintisiz Çözüm
- Taşınabilir Sahra Konteyner ModelYüksek Kapasiteli, Güvenilir ve Endüstriyel Ölçekli Çözümler
- Hastane-Tesis ModelYüksek Kapasiteli, Güvenilir ve Endüstriyel Ölçekli Çözümler
- Tümünü Görüntüle
- PSA Azot JeneratörleriYüksek Kapasiteli, Güvenilir ve Endüstriyel Ölçekli Çözümler
- Entegre Sistemler
- Çözümler
- İletişim
© 2025 Tesa Medikal - Her hakkı saklıdır.
E-Bülten
Oxyvital E-Bülteni ile
Güncel Kalın
Oxyvital dünyasındaki yeniliklerden, fuar katılımlarından ve teknik içeriklerden haberdar olmak için bültenimize kayıt olun.